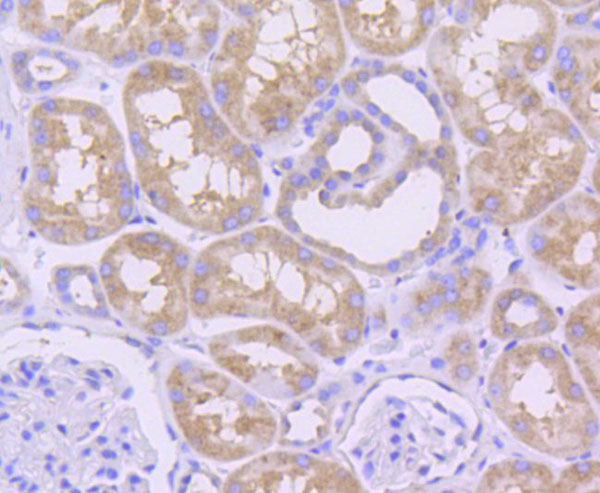

Filters
Clonality
Type
Reactivity
Gene Name
Isotype
Host
Application
Clone
45 results for " Bcl2" - showing 1-45
Apoptosis regulator BAX, ELISA Kit (Cat# AAA23197)
Beclin 1, ELISA Kit (Cat# AAA16194)
BAX, Polyclonal Antibody (Cat# AAA29799)
Apoptosis regulator Bcl-2, ELISA Kit (Cat# AAA23184)
B-Cell Activation Factor, ELISA Kit (Cat# AAA17036)
Bax, ELISA Kit (Cat# AAA21847)
Induced myeloid leukemia cell differentiation protein Mcl-1, ELISA Kit (Cat# AAA17552)
BAX, Polyclonal Antibody (Cat# AAA29801)
Beclin 1, ELISA Kit (Cat# AAA16637)
BCL2, Polyclonal Antibody (Cat# AAA28239)
BCL2, Polyclonal Antibody (Cat# AAA29670)
BECN1, Polyclonal Antibody (Cat# AAA23584)
BAG3, Polyclonal Antibody (Cat# AAA30572)
BAG1, Monoclonal Antibody (Cat# AAA24736)
BAG1, Monoclonal Antibody (Cat# AAA24441)
Beclin-1, Polyclonal Antibody (Cat# AAA10959)
MCL1, Recombinant Protein (Cat# AAA11824)
Bcl-2, Polyclonal Antibody (Cat# AAA30544)
MCL1, Polyclonal Antibody (Cat# AAA10630)
Bcl2 Associated X Protein (Bax), Recombinant Protein (Cat# AAA21110)
BAG1, Polyclonal Antibody (Cat# AAA10702)
BAG1, Polyclonal Antibody (Cat# AAA29663)
MCL1 , Monoclonal Antibody (Cat# AAA28233)
BNIP3, Monoclonal Antibody (Cat# AAA30339)
MCL1, Monoclonal Antibody (Cat# AAA30035)
BAG1, Monoclonal Antibody (Cat# AAA25622)
BAG1, Monoclonal Antibody (Cat# AAA25033)
BAG1, Monoclonal Antibody (Cat# AAA24146)
PUMA, Polyclonal Antibody (Cat# AAA29955)
BAG1, Monoclonal Antibody (Cat# AAA25329)
BOK, Polyclonal Antibody (Cat# AAA28329)
PUMA, Monoclonal Antibody (Cat# AAA29989)
BAX, Monoclonal Antibody (Cat# AAA30009)
BCL-XL, Monoclonal Antibody (Cat# AAA30008)
BCL-2, Monoclonal Antibody (Cat# AAA30284)
BCL-2, Monoclonal Antibody (Cat# AAA30003)
Bax, Polyclonal Antibody (Cat# AAA28318)
BAG3, Polyclonal Antibody (Cat# AAA31421)
Predicted Reactivity: Pig (100%), Bovine (100%), Horse (100%), Sheep (100%), Rabbit (100%), Dog (100%)
PUMA, Polyclonal Antibody (Cat# AAA10943)
BCLAF1, Polyclonal Antibody (Cat# AAA31422)
Predicted Reactivity: Pig (100%), Bovine (100%), Horse (100%), Sheep (100%), Rabbit (100%), Dog (100%), Chicken (100%)
Bik, Polyclonal Antibody (Cat# AAA11666)
BAK, Polyclonal Antibody (Cat# AAA11654)
PUMA, Polyclonal Antibody (Cat# AAA10934)
Bcl-2, Polyclonal Antibody (Cat# AAA31360)
Predicted Reactivity: Pig (86%), Bovine (83%)